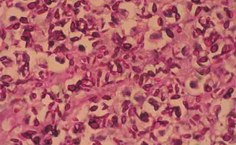
Histopatologico fotomicrografia de material cutâneo do do gato portador de esporotricose comprovando presença abundante do fungo

Pesquisadores identificam micose transmitida ao homem por felino doméstico em Alagoas
Denominada de esporotricose, a micose subcutânea tem no gato um potencial transmissor para o ser humano
- Atualizado em

Diana Monteiro – jornalista
Diversas zoonoses podem ser transmitidas por cães ou gatos e, entre essas, uma que tem tido destaque é a esporotricose, uma micose subcutânea causada pelo fungo Sporothrix schenckii, cujos relatos dos últimos anos trazem o gato doméstico como potencial transmissor para o ser humano e alertam sobre os riscos do ponto de vista de saúde pública.
O fungo cresce no solo, casca de árvores, espinhos de roseira, feno e vegetações em decomposição, podendo infectar várias espécies animais incluindo o homem. Os gatos apresentam particularidades que os tornam mais susceptíveis ao fungo, adotando posição fundamental na epidemiologia dessa micose em razão de seu comportamento natural de afiar as unhas em árvores e cavar o solo para enterrar suas fezes, permitindo assim o abrigo do fungo em localização unguea (unha).
Como agravante, os gatos infectados apresentam na pele uma carga exuberante de Sporothrix schenckii nas secreções de feridas ulceradas, sendo este fator o que potencializa a transmissão tanto entre os gatos quanto entre outras espécies, sobretudo ao homem na manipulação do animal. Atualmente há descrição de casos da esporotricose em vários estados brasileiros como Espírito Santo (15 casos); Paraná (16 casos); Minas Gerais (17 casos); São Paulo (18 casos); e Amazônia (19 casos); Rio Grande do Sul (7 casos) e em Santa Catarina (2 casos). No Rio de Janeiro, a doença descrita como surto, atingiu proporções epidêmicas alarmantes, com envolvimento de gatos e pessoas e foram confirmados até 2009 cerca de 2.200 casos humanos.
O primeiro relato de caso da esporotricose no Estado foi feito recentemente por pesquisadores do curso de Medicina Veterinária da Universidade Federal de Alagoas (Ufal) em um felino macho, da raça siamês atendido no consultório do Núcleo de Educação Ambiental Francisco de Assis (Neafa). O animal com cinco anos de idade, apenas vacinado contra raiva, veio a óbito e apresentava na cabeça e nos membros, lesões ulceradas e nodulares com presença de intenso prurido. O proprietário também apresentava as lesões nodulares no local da arranhadura feita pelo animal de estimação.
Denominado de Felino doméstico como agente transmissor de esporotricose para humano: relato do primeiro caso no Estado de Alagoas, o estudo científico contou com a participação dos pesquisadores Evelynne Hildegard Marques Melo; Diego Fernando da Silva Lessa, Anelise Castanha Barreto Tenório Nunes; Karla patrícia Chaves, Wagner José Nascimento Porto, Márcia Kikuyo Notomi e Lúcia Helena Alberto Garrido, que coordena o Hospital Veterinário da Faculdade de Jaguariuna (São Paulo).
O relato científico objetiva alertar os médicos veterinários sobre a importância do diagnóstico precoce da esporotricose em gatos, e aos profissionais da área de Saúde o papel do gato doméstico na transmissão da enfermidade. “Alagoas é área endêmica para o fungo causador dessa dermatozoonose devido ao clima favorável e que provavelmente vem sendo sub - diagnosticada. Vários Estados já haviam relatado esse agravo zoonótico, como alerta, surto ou epidemia, mas no entanto, Alagoas ainda não havia essa divulgação”, frisou Evelynne Marques, coordenadora de estagiários no Neafa com formação em clínica e cirurgia geral de cães e gatos pelo Instituto Qualittas, de São Paulo.
Na infecção humana, a esporotricose, é considerada uma enfermidade relacionada com profissionais que mantêm contato com o ambiente do fungo, como jardineiros, horticultores e agricultores, ou como doença de caráter zoonótico ocupacional, sendo grupo de risco os profissionais da área Veterinária, como médicos, enfermeiros e estudantes. “É importante a investigação da dermatozoonose que vai além de uma doença ocupacional, acometendo também os proprietários dos animais dentro do ambiente doméstico”, reforçou Evelynne.
Avaliação do felino
Apresentando condição corpórea debilitada e apático e temperatura de 40°C, o animal com desidratação intensa, estava com aumento dos linfonodos mandibulares e secreção nasal sanguinolenta. No exame dermatológico foram observadas lesões generalizadas por toda a cabeça apresentando-se na forma de nódulos ulcerados e fístulas drenando secreção purulenta. Também estava acometido de necrose nas extremidades das orelhas e lesões ulceradas na porção distal de dígitos dos membros torácicos. O exame histológico no material coletado do animal os pesquisadores constataram o indicativo da doença esporotricose.
O dono do animal, que ainda está sob tratamento médico, apresentava uma lesão nodular com secreção purulenta no dedo da mão esquerda após arranhadura do animal também com lesões satélites no braço e antebraço. Foram feitas as culturas bacteriana e fúngica, constatando-se o diagnóstico de esporotricose na forma linfocutânea. O proprietário do animal, um homem de 30 anos de idade sem o histórico de atividades ligadas ao solo ou plantas, manifestou uma lesão nodular com secreção. O tratamento instituído é à base do antifúngico itraconazol 400 mg/dia.
Incidência e prevenção
Segundo os pesquisadores, a elevação no número de casos no Brasil pode estar relacionada à presença de um elevado número de animais semidomiciliados e errantes, somada ao clima quente tropical e semitropical do país, fatores que determinam condições favoráveis ao desenvolvimento de Sporothrix schenckii, aumentando o risco de infecção tanto em animais quanto em seres humanos.
A esporotricose deve ser incluída no diagnóstico diferencial das dermatopatias com lesões nodulares exsudativa tanto em animais quanto em seres humanos que tenham contato com animais. Adicionalmente, ressalta-se a necessidade de o médico veterinário suspeitar e realizar um rápido diagnóstico, principalmente em gatos por causa de seu alto potencial transmissor, prevenindo a transmissão de doenças a seres humanos e outros animais.
Os pesquisadores reforçam que para um diagnóstico precoce e prevenção de novas infecções, há a necessidade de atualização dos profissionais da área da Saúde Humana e Veterinária, principalmente, por ser tratar de uma enfermidade de difícil tratamento pela longa duração e pelos efeitos colaterais frequentes. “Deve-se considerar também o possível comprometimento estético ou psicológico decorrente das cicatrizes em seres humanos e o elevado risco de morte em animais”, destacaram.